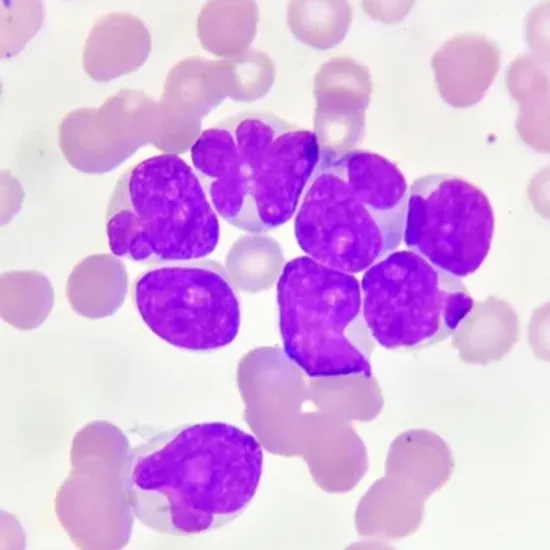

Book AML (Acute myeloid leukaemia) Categorization Prognosis Test Appointment Online Near me at the best price in Delhi/NCR from Ganesh Diagnostic. NABL & NABH Accredited Diagnostic centre and Pathology lab in Delhi offering a wide range of Radiology & Pathology tests. Get Free Ambulance & Free Home Sample collection. 24X7 Hour Open. Call Now at 011-47-444-444 to Book your AML (Acute myeloid leukaemia) Categorization Prognosis Test at 50% Discount.
Book AML (Acute myeloid leukaemia) Categorization Prognosis Test at the best price in Delhi NCR, India from GDIC (Ganesh Diagnostic & Imaging Centre). GDIC is a NABL Accredited Pathology lab in Delhi offering a wide range of blood testing services.
The subtype of AML can be useful in determining a person's prognosis (outlook). However, other factors can influence why some AML patients have a better prognosis than others. These are known as prognostic factors. Prognostic factors help doctors predict whether a person's leukaemia will recur after treatment.
Acute myeloid leukaemia (AML), on the other hand, usually does not form tumours. It is generally found throughout the bone marrow and has spread to other organs such as the liver and spleen in some cases. As a result, unlike most other cancers, AML is not staged. The prognosis of an AML patient is determined by other factors such as the subtype of AML (determined by lab tests), the patient's age, and other lab test results.
This test is used for immunophenotyping – classifying leukaemia cells according to the substances (antigens) on their surfaces.
Need to provide blood.
No preparation is needed.
* A doctor's prescription.
* A valid government ID.
No care is required.
The AML (Acute myeloid leukaemia) Categorization Prognosis Test costs vary by region and facility. So, get tested at trustworthy diagnostic centre like Ganesh Diagnostic. Training and experienced professionals are staffed to assure patient and visitor safety.
| Test Type | AML (Acute myeloid leukaemia) Categorization Prognosis Test |
| Includes | AML (Acute myeloid leukaemia) Categorization Prognosis Test (Pathology Test) |
| Preparation | |
| Reporting | Within 24 Hours*. |
| Test Price |
₹ 4000
|

Early check ups are always better than delayed ones. Safety, precaution & care is depicted from the several health checkups. Here, we present simple & comprehensive health packages for any kind of testing to ensure the early prescribed treatment to safeguard your health.